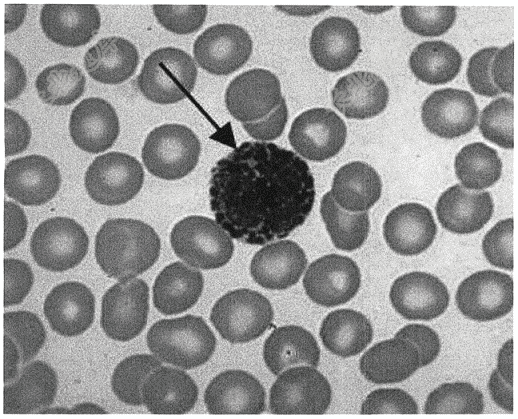

试题详情
- 简答题请报告箭头所指细胞的名称
关注下方微信公众号,搜题查看答案

热门试题
- 心电图检查最可能的是( )
- 女,42岁,左髋疼痛30余年,加重3月为
- 下列心电图检查最可能的是( )
- 下列心电图检查最可能的是( )
- 患者,女,60岁,间断胸闷2年
- 请选出正确诊断( )
- 下列心电图诊断最可能的是( )
- 请指出下列血气分析中哪一项是Ⅰ型呼吸衰竭
- 男性,51岁( )
- 男性,55岁,嗽咳、咳血1月( )
- 请选出正确诊断)
- 患者,47岁,活动后出现呼吸困难一年余。
- 患者男,62岁。腹胀、腹痛4天。诊断:
- 患者,女,41岁,主诉"发现左颈无痛性质
- 患者,男,50岁,突发心慌1小时 <
- 患者男,68岁,反复胸闷气促12年,加重
- 请选出正确答案( )
- 男性患者,65岁,因右侧肢体乏力一天,突
- 患者男,48岁。健康体检化验。诊断:
- 青年女性,28岁,因发现右乳肿物1周入院